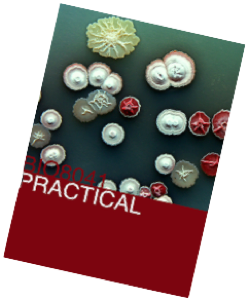

The practical makes up 60% of the assessment for this module
Please read the practical instruction manual prior to coming to the labs.
In this practical you will be repeating on a small scale the methods used in the early stages of antibiotic drug discovery: The genesis of 'Golden Age of Drug Discovery" was the identification of antimicrobial compounds from bacteria and fungi. The majority of novel antibiotics were discovered from the genus Streptomyces isolated from soil samples. Today ca. 70% of antibiotics on the market are derived from bacteria, many going to market unmodified! This practical aims to give you an appreciation of the initial stages of discovery: the isolation and screening of Streptomyces species for antibiotic activity.


Practical Report

Analysis of Zones of Inhibition (ZoI) data
Error bars in experimental biology
An excellent paper describing how to correctly use and interpret error bars